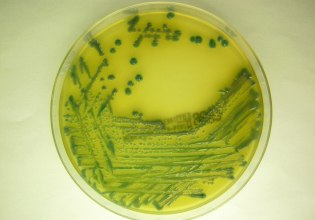
Μείωση 40% των νοσοκομειακών λοιμώξεων απέτρεψε 17.000 μέρες νοσηλείας επιπλοκών

Μικρές διακυμάνσεις στις διεθνείς αγορές τη Δευτέρα
Μεικτές τάσεις χωρίς σημαντικά κέρδη καταγράφηκαν τη Δευτέρα στην Ευρώπη και στις ΗΠΑ.
-
Νέα σκληρή επίθεση Τραμπ στην Ευρώπη
-
«Απόλυτη φρίκη» στο Σουδάν – Μαζικός βιασμός 19 γυναικών που προσπαθούσαν να φύγουν από το Ελ Φασέρ
-
Σαρκοζί: Άνοιγμα στη Λεπέν – Ο Εθνικός Συναγερμός «δεν αποτελεί κίνδυνο» για τη Γαλλία, λέει
-
Αλέξης Χαρίτσης: Η κυβέρνηση κυνηγά τους αγρότες και καλύπτει την πραγματική εγκληματική οργάνωση
Μεικτές τάσεις χωρίς σημαντικά κέρδη καταγράφηκαν τη Δευτέρα στην Ευρώπη και στις ΗΠΑ.
Πτώση 0,30% στις 15612,10 μονάδες είχε ο Dow Jones και 0,19% στις 1706,48 μονάδες ο Standard & Poor’s.
Οριακή άνοδο 0,09% στις 3692.95 μονάδες είχε ο Nasdaq.
Στο Λονδίνο ο FTSE υποχώρησε 0,43% στις 6.619,58 μονάδες και στη Φρανκφούρτη ο DAX υποχώρησε 0,10 στις 8.398,38 μονάδες.
Άνοδο 0,11% είχε στο Παρίσι ο CAC στις 4.049,97 μονάδες και 0,19% στη Ζυρίχη ο SMI για να διαμορφωθεί στις 7.979,40 μονάδες.
Newsroom ΑΛΤΕΡ ΕΓΚΟ
- Τι αλλάζει με τα πρόστιμα για όσους δεν πληρώσουν έγκαιρα τα τέλη κυκλοφορίας
- Τεχνητή Νοημοσύνη: «Βλέπει» φτωχά και πλούσια έθνη;
- Μείωση 40% των νοσοκομειακών λοιμώξεων απέτρεψε 17.000 μέρες νοσηλείας επιπλοκών
- Συνταγή: Τονοσαλάτα με καστανό ρύζι, ρόδι, σταφίδα & λαχανικά
- Πόσο Τραμπ μπορεί να αντέξει η Ευρώπη;
- Copernicus: Το 2025 αναμένεται να είναι το δεύτερο θερμότερο έτος που καταγράφτηκε ποτέ
- Είναι ο χυμός παντζαριού το καλύτερο πρωινό ρόφημα που δεν ήξερες;
- Καιρός: Τοπικές βροχές σε αρκετές περιοχές – Πού θα έχει καταιγίδες
Ακολουθήστε το in.gr στο Google News και μάθετε πρώτοι όλες τις ειδήσεις


![Άκρως Ζωδιακό: Τα Do’s και Don’ts στα ζώδια σήμερα [Τρίτη 09.12.2025]](https://www.in.gr/wp-content/uploads/2025/12/astronomy-3094066_1920-315x220.jpg)

Αριθμός Πιστοποίησης Μ.Η.Τ.232442